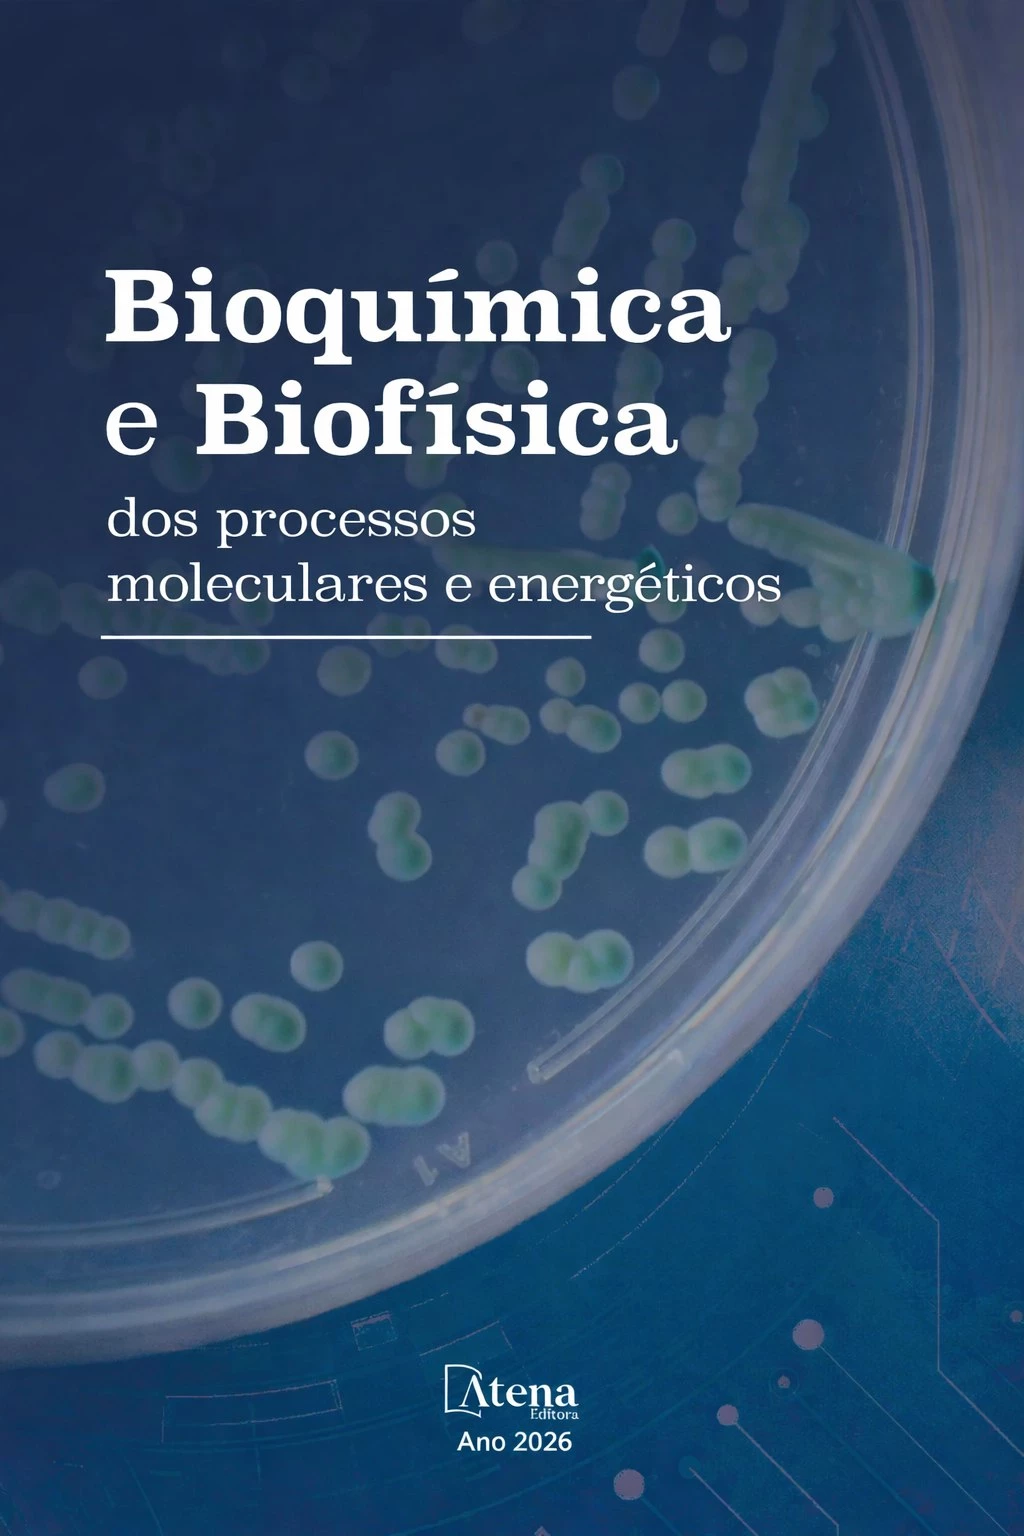
capa do ebook Bioquímica e Biofísica dos processos moleculares e energéticos

Bioquímica e Biofísica dos processos moleculares e energéticos
Prezados Autores,
É com grande satisfação que damos as boas-vindas a todos os profissionais, pesquisadores e estudantes das áreas de Ciências Biológicas e da Saúde que escolheram integrar este projeto editorial voltado à obra Bioquímica e Biofísica dos Processos Moleculares e Energéticos. Na Atena Editora, temos o compromisso de fomentar a disseminação do conhecimento científico de forma acessível, atual e de qualidade.
Esta obra reúne contribuições relevantes que abordam os fundamentos da bioquímica e da biofísica, explorando os mecanismos moleculares e os processos energéticos que sustentam a vida. Os capítulos contemplam desde a estrutura e função de biomoléculas até as complexas vias metabólicas e suas interações, promovendo uma compreensão integrada e aprofundada dos sistemas biológicos.
O modelo de publicação em fluxo contínuo adotado pela editora proporciona maior agilidade na divulgação científica, permitindo que pesquisas e estudos sejam compartilhados de maneira mais rápida com a comunidade acadêmica e profissional. Essa dinâmica contribui diretamente para o avanço do conhecimento e para a atualização constante nas áreas de estudo contempladas pela obra.
Ao reunir diferentes perspectivas e abordagens, este livro se consolida como uma importante fonte de consulta e aprendizado, contribuindo para o desenvolvimento científico e acadêmico, além de apoiar a formação de profissionais mais preparados para os desafios contemporâneos.
Agradecemos a confiança depositada em nosso trabalho e esperamos que esta publicação seja uma ferramenta valiosa na trajetória de todos os envolvidos.
Atenciosamente,
Atena Editora.
Bioquímica e Biofísica dos processos moleculares e energéticos
-
DOI: https://doi.org/10.22533/at.ed.22911261004
-
ISBN: 978-65-258-4122-9
-
Palavras-chave: 1. Bioquímica. 2. Biofísica. 3. Processos moleculares. I. Atena Editora (Organização). II. Título.
-
Ano: 2026
- Amanda de Andrade Marques
- Ana Carolina Ferreira Araújo
- Antonio Júdson Targino Machado
- Bruna Dantas Nogueira
- Caio César Vieira Rocha
- Dannily Augusto Rebouças
- Dárcio Luiz de Sousa Júnior
- Davyson de Lima Moreira
- Eloisa Maria Pereira Neves
- Gabriela Felix Leite
- Janeanne Nascimento Silva Lopes
- Jéssica Sales Felisberto
- Lina da Silva Florencio
- Marina Micaelle Rodrigues Siqueira
- Paulo Henrique Carvalho Silveira
- Raimundo Luiz Silva Pereira
- Ygor Jessé Ramos


